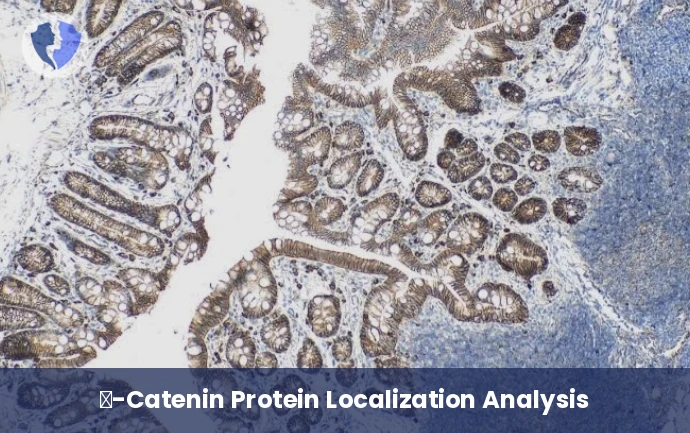
Detecting Genetic Defects in Tumors - Immunohistochemistry: β-Catenin

Service Details
Detecting Genetic Defects in Tumors - Immunohistochemistry: β-Catenin
Immunohistochemical assay (IHC) assesses the expression pattern and intracellular localization of the protein β-catenin. Normally, β-catenin is found in the cell membrane (associated with icadaherin) and in the cytoplasm. In cases of activating mutations in the CTNNB1 gene (which encodes β-catenin) or in the Wnt pathway, the protein accumulates in and translocates to the nucleus. This assay is used as a diagnostic marker for tumors associated with Wnt/β-catenin pathway mutations, most notably desmoid fibromatosis. It is also useful in liver tumors such as hepatocellular adenoma and certain subtypes of hepatocellular carcinoma, as well as in some gastrointestinal tumors.